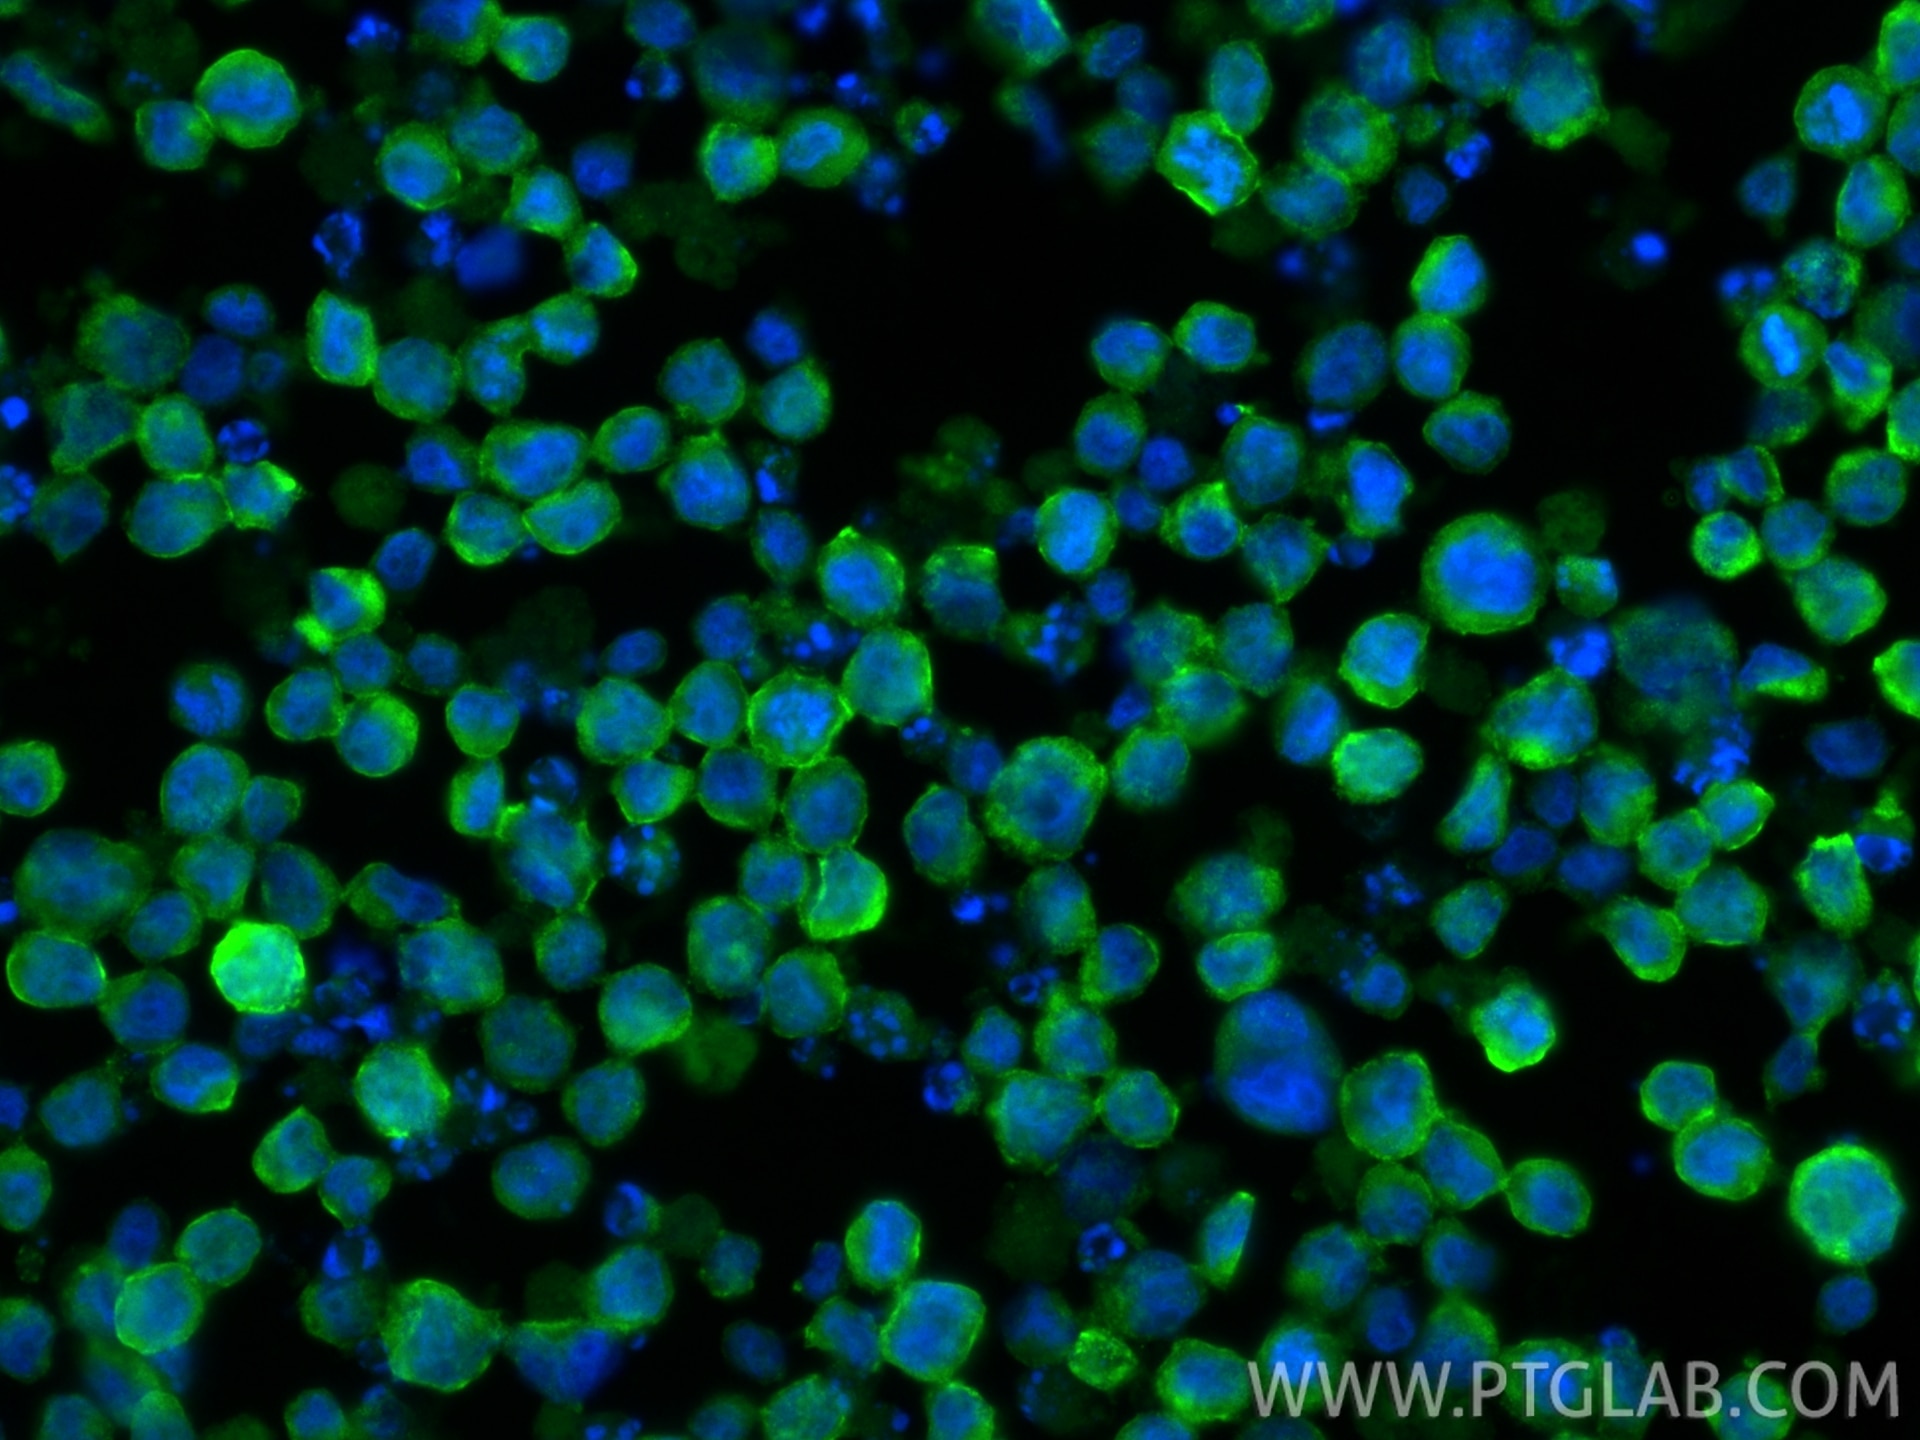
Immunofluorescence (IF) / fluorescent staining of HL-60 cells using RAB3D Polyclonal antibody (12320-1-AP)

Tested Applications
| Positive WB detected in | mouse lung tissue, A549 cells, human cerebellum tissue, human stomach tissue, mouse spleen tissue, mouse stomach tissue, SW 1990 cells |
| Positive IP detected in | SW 1990 cells |
| Positive IHC detected in | human prostate cancer tissue, human breast cancer tissue Note: suggested antigen retrieval with TE buffer pH 9.0; (*) Alternatively, antigen retrieval may be performed with citrate buffer pH 6.0 |
| Positive IF/ICC detected in | HL-60 cells |
Recommended dilution
| Application | Dilution |
|---|---|
| Western Blot (WB) | WB : 1:500-1:2400 |
| Immunoprecipitation (IP) | IP : 0.5-4.0 ug for 1.0-3.0 mg of total protein lysate |
| Immunohistochemistry (IHC) | IHC : 1:400-1:1000 |
| Immunofluorescence (IF)/ICC | IF/ICC : 1:50-1:500 |
| It is recommended that this reagent should be titrated in each testing system to obtain optimal results. | |
| Sample-dependent, Check data in validation data gallery. | |
Published Applications
| KD/KO | See 1 publications below |
| WB | See 10 publications below |
| IHC | See 9 publications below |
| IF | See 6 publications below |
Product Information
12320-1-AP targets RAB3D in WB, IHC, IF/ICC, IP, ELISA applications and shows reactivity with human, mouse, rat samples.
| Tested Reactivity | human, mouse, rat |
| Cited Reactivity | human, mouse, rat, pig, canine, goat |
| Host / Isotype | Rabbit / IgG |
| Class | Polyclonal |
| Type | Antibody |
| Immunogen |
CatNo: Ag2973 Product name: Recombinant human RAB3D protein Source: e coli.-derived, PGEX-4T Tag: GST Domain: 1-219 aa of BC016471 Sequence: MASAGDTQAGPRDAADQNFDYMFKLLLIGNSSVGKTSFLFRYADDSFTPAFVSTVGIDFKVKTVYRHDKRIKLQIWDTAGQERYRTITTAYYRGAMGFLLMYDIANQESFAAVQDWATQIKTYSWDNAQVILVGNKCDLEDERVVPAEDGRRLADDLGFEFFEASAKENINVKQVFERLVDVICEKMNESLEPSSSSGSNGKGPAVGDAPAPQPSSCSC Predict reactive species |
| Full Name | RAB3D, member RAS oncogene family |
| Calculated Molecular Weight | 219 aa, 24 kDa |
| Observed Molecular Weight | 24-27 kDa |
| GenBank Accession Number | BC016471 |
| Gene Symbol | RAB3D |
| Gene ID (NCBI) | 9545 |
| RRID | AB_2177228 |
| Conjugate | Unconjugated |
| Form | Liquid |
| Purification Method | Antigen affinity purification |
| UNIPROT ID | O95716 |
| Storage Buffer | PBS with 0.02% sodium azide and 50% glycerol, pH 7.3. |
| Storage Conditions | Store at -20°C. Stable for one year after shipment. Aliquoting is unnecessary for -20oC storage. 20ul sizes contain 0.1% BSA. |
Background Information
Rab3D is a member of the Rab3 subfamily, which comprises four isoforms (Rab3A, Rab3B, Rab3C, and Rab3D). Rab3 proteins typically associate with secretory vesicles, including synaptic vesicles, and have been implicated in the control of regulated exocytosis. Rab3D is widely expressed in adipocytes, exocrine glands and several haematopoietic cells, where it localizes to secretory granules and vesicles.
Protocols
| Product Specific Protocols | |
|---|---|
| IF protocol for RAB3D antibody 12320-1-AP | Download protocol |
| IHC protocol for RAB3D antibody 12320-1-AP | Download protocol |
| IP protocol for RAB3D antibody 12320-1-AP | Download protocol |
| WB protocol for RAB3D antibody 12320-1-AP | Download protocol |
| Standard Protocols | |
|---|---|
| Click here to view our Standard Protocols |
Publications
| Species | Application | Title |
|---|---|---|
Blood A novel cause of type 1 von Willebrand disease: impaired exocytosis of Weibel-Palade bodies due to biallelic MADD variants | ||
Mol Metab Maternal hyperglycemia induces alterations in hepatic amino acid, glucose and lipid metabolism of neonatal offspring: Multi-omics insights from a diabetic pig model | ||
Sci Signal RhoA inhibits neural differentiation in murine stem cells through multiple mechanisms. | ||
Mol Cancer Secretory RAB GTPase 3C modulates IL6-STAT3 pathway to promote colon cancer metastasis and is associated with poor prognosis. | ||
PLoS One Accumulation of secretory vesicles in the lacrimal gland epithelia is related to non-Sjögren's type dry eye in visual display terminal users. | ||
Am J Physiol Gastrointest Liver Physiol Establishment of novel in vitro mouse chief cell and SPEM cultures identifies MAL2 as a marker of metaplasia in the stomach. |
Reviews
The reviews below have been submitted by verified Proteintech customers who received an incentive for providing their feedback.
FH Kamal (Verified Customer) (02-15-2024) | Rab3D antibody showed strong bands on western blot with fewer non-specific bands. This antibody was dilutedn1:2000 in 1X TBST.
|
FH robert (Verified Customer) (06-13-2022) | This Rab3D antibody worked well for both immunoblotting and immunocytochemistry with gastric cancer cell lines. I tried others from other companies, but this antibody worked best.
|
FH Robert (Verified Customer) (01-24-2019) | This Rab3D antibody delivered a strong signal on Western Blots and fewer non-specific bands than other commercial Rab3D antibodies I've used. It was sensitive and specific. I may increase the dilution to 1:2000 and see how that works.
|